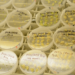
What to Look for When Investing in a Biotech Startup

Twitter recently ditched its star-shaped ‘favorite’ button for the more familiar heart-shaped like button. In a blog post, the company said, “you might like a lot of things, but not everything can be your favorite.” And that is a fair point. On social media, a lot of people like A LOT of things.
The bigger and more interesting question here is about the evolution of Twitter and what this small change means for the platform’s next steps. Recently, one of Twitter’s oldest and biggest investors, Chris Sacca, wrote a long-form blog post outlining what he sees as the company’s future, and indeed, doing away with the ‘star’ was one of those things.
So, what else does the Silicon Valley star have in mind for Twitter? I read the whole post so you do not have to.
First, he admits that in contrast to other mega-popular platforms that have arisen, Twitter “has failed to tell its own story.” It has really acted as a blank canvas for communities in general to make their feelings known, and for stories to get legs of their own.
For Wall Street, things have been disappointing. However, for most of us here on Main Street, the outlook is good. Product innovations are happening quicker than ever before, and we could see big changes sooner than later. Sacca says that change can not happen slowly: “Instead, Twitter will need to take huge risks, deeply question its key assumptions, and launch materially new stuff early and often.”
Everything you could want, regardless of your interest, is there. But making the most out of the platform takes more work than many are willing to do. Could we see Twitter turn to an algorithm or present an algorithmic feed option so users can more easily have a curated, Facebook-like experience? Sacca admits that most users do not care how old or by whom a tweet was posted, “they just want the best stuff.”
Sacca recommends three adjustments to the core product: Live, Channels, and a Save Button. He rightly says, “Everything that is happening is happening on Twitter. Every game, every show, every debate, every war, every storm, every ceremony, every tragedy, every election.” Indeed, “live-tweet” already lives in the Oxford English Dictionary. Yet a separate “Live Twitter” tab could make Twitter an even more integral part of live, cultural events by curating tweets by key influencers, commenters, or people present at the event.
Channels are a way to use curation to dampen the noise of the howling abyss most Twitter newbies hear when they log in. People know what TV channels they like to watch, and they know what magazines they want to buy. Channels is a potential way to remove some of the anxiety of choice and replace it with relevant, timely content sorted by topic, location, and popularity. The curation of these channels would be algorithmic but also feature a human editorial component.
The Save button “would let you keep all the good stuff.” Although all your favorites—err, likes—are kept saved, this function allows users to be a bit more comfortable when it comes to dealing with all the noise. They can be sure that they can save something and find it later should they wish to just continue browsing. Beyond being just another depository for things you like, it is unclear to me how the functionality would differ from the ‘likes’ that are saved.
Ultimately, Sacca’s goal for Twitter is for the platform to become a place of functionality where prospective users are no longer likely to say things like, “I wouldn’t know what to Tweet. I don’t really have anything to say.” He’s right when he asserts that Twitter can be an intimidating place. All the people with thousands of followers, dozens of retweets. Yet the truth is that you do not need to have any followers or tweet anything to get value out of the platform.
However, there are plenty of potential (and some already implemented) ways Twitter can solicit its users’ participation without all of them having to tweet about their opinions. Twitter polls are a recently unveiled way for users to participate and make their opinions known without actually having to send a tweet.
I think the vision that Sacca has for the future of Twitter shows that, despite the initial disappointment of investors, for those of us whose only benefit is its utility, there continues to be a bright future. Twitter may not look exactly as Sacca outlined in his post, but if the company’s commitment to innovation is anywhere near its top investors, we will be using Twitter for a long time to come.
Image credit: CC by Miha Filej